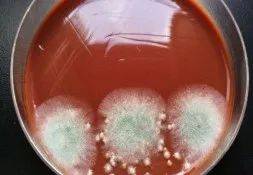
抵抗力|肺发霉？！杭州女子反复咳嗽10多年，医生从肺里“挖”出“臭鸡蛋”

抵抗力|肺发霉?!杭州女子反复咳嗽10多年,医生从肺里“挖”出“臭鸡蛋”
发霉的面包 , 发霉的水果 , 发霉的木头······夏天湿热 , 很多东西都容易发霉长毛 。 可没想到的是 , 淳安章阿姨(化名)的肺竟然发霉了!而且 , 一发霉就是10年!
【抵抗力|肺发霉?!杭州女子反复咳嗽10多年,医生从肺里“挖”出“臭鸡蛋”】反复咳嗽10多年 , 竟是肺发霉了
章阿姨年轻时就长得瘦瘦小小 , 1米6不到的身高 , 体重刚过80斤 。 别人都是中年发福 , 可她过了40岁后却越来越瘦 。 原来 , 章阿姨有个纠缠她多年的老毛病 , 让她茶饭不思 , 寝食难安 。
章阿姨还记得 , 那天她正吃着饭 , 突然一阵剧烈的咳嗽 , 以为是呛到了 , 她赶紧喝了几口水 。 但是没多久又咳嗽起来 , 反反复复 , 有时还会咳出血来 , 尤其夜间干咳 , 让她经常睁眼到天亮 。
她曾到当地多家医院求诊 , 医生都是按“支气管炎、慢性咽炎”治疗 , 开了不少止咳化痰的药 。 但这么多年下来 , 吃下去的药论斤称 , 却总不见好 。 这一咳 , 就是10年 。 长期的折磨 , 让章阿姨看着就比同龄人衰老10多岁 。
之后 , 章阿姨来到了杭州市第一人民医院心胸外科 , 接诊的是副主任医师冯兴 。 一番详细的检查后 , 医师告诉章阿姨:“你的肺已经发霉了!”

文章图片
感染曲霉菌 , 整个左肺快要“沦陷”
原来 , 章阿姨得的是肺曲霉病 。 “这个病比较罕见 , 即使在市一医院这种三级综合性医院中 , 一年也很难遇到几个 。 ”冯兴介绍 。
曲霉菌主要存在于土壤、空气、植物、野生或家禽动物及飞鸟的皮毛 , 也常见于农田、马棚、牛栏、谷仓等处 。 当机体抵抗力降低时 , 病原菌可经皮肤黏膜损伤处或吸入呼吸道 , 最常侵犯支气管和肺 , 进而进入血液循环到其他组织或器官 。
据章阿姨回忆 , 自己年轻时曾在煤矿场上班 。 煤矿厂环境潮湿、阴暗 , 在这种环境中 , 她一做就是二十年 。 正因为如此 , 曲霉菌在章阿姨的支气管和肺部扎根、发芽、霉变 。
因为曲霉菌的感染和侵蚀 , 章阿姨左肺上叶已经出现了一处鸡蛋大小的空洞 , 而且正在慢慢变大 , 再发展下去可能整个左肺都要“沦陷”!
医师立刻予以抗真菌药治疗 , 使之在肺内形成了稳定的曲菌球团 , 并安排住进病房 , 准备择期手术 。
立马手术 , 肺里“挖”出“臭鸡蛋”

文章图片
打开胸腔后 , 医生们发现章阿姨的左侧全胸腔粘连 , 他们在左肺上叶发现了一个直径约5cm大小的窟窿 , 里面堵着一个青灰色豆腐渣样的“鸡蛋” , 一阵恶臭味袭来 。
折磨章阿姨10多年的罪魁祸首被“揪”出来了 , 就是这曲霉菌球!
文章图片
术后 , 章阿姨恢复良好 。
曲霉菌普遍存在 , 如何预防感染?
曲霉菌在自然界中存在感如此之强 , 平时我们又该如何做好防护呢?

文章图片
冯兴介绍 , 最重要的是要提高自身的抵抗力 , 例如多参加体育锻炼等 。 抵抗力低的人群可以在医生指导下适当服用增强抵抗力的药物 。
另外 , 真菌感染和环境有一定关系 , 大家要做好以下几点:
做好居家清洁工作 , 定期晾晒被褥 , 勤打扫 , 及时清理发霉物品 。
家中或办公室注意通风 , 尤其在梅雨季节 。
- 肺炎|遵义120教你肺炎伴胸膜炎怎么办
- 心脑血管|大荔中医医院脾胃肺病科“妙手回春”受到患者的称赞
- 小儿咳嗽可不都是肺热?小儿咳嗽也分好多种,你知道吗
- 预防肿瘤|夜里温度下降孩子睡不好,多吃营养菜,补虚暖胃,提高抵抗力
- 领导|邵阳召开强化新冠肺炎定点救治医院管理工作视频会议
- 报告|16日15时-24时,珠海新增3例新冠肺炎确诊病例,详情公布
- 防控|【北京疾控提醒您】关于本市海淀区新冠肺炎确诊病例的溯源情况通报
- 感染者|地坛医院在院新冠肺炎患者15例,其中奥密克戎感染者6例
- 珠海|广东珠海新增2例新冠肺炎确诊病例 将启动连续三轮全员核酸检测
- 证券时报网|我国已累计向120多个国家和国际组织提供超过20亿剂新冠肺炎疫苗
